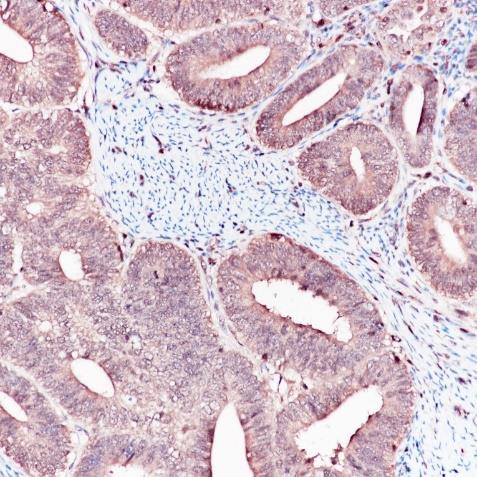

ERK2 Rabbit Monoclonal Antibody(ARA773)
CAT.NO. : ARA6560
RMB Please choose
RMB Please choose
Size:
Trail, Bulk size or Custom requests Please contact us
Background
Serine/threonine kinase which acts as an essential component of the MAP kinase signal transduction pathway. MAPK1/ERK2 and MAPK3/ERK1 are the 2 MAPKs which play an important role in the MAPK/ERK cascade. They also participate in a signaling cascade initiated by activated KIT and KITLG/SCF. Depending on the cellular context, the MAPK/ERK cascade mediates diverse biological functions such as cell growth, adhesion, survival and differentiation through the regulation of transcription, translation, and cytoskeletal rearrangements.
Application
|
Application |
Dilution Ratio |
|
WB |
1:1,000 - 1:2,000 |
|
IHC-P |
1:800 - 1:1,600 |
|
IP |
1:10 - 1:20 |
|
FC |
1:200 - 1:1,000 |
|
ICC/IF |
1:50 - 1:200 |
Overview
|
Predicted Molecular Weight |
41kDa |
|
Species Cross-reactivity |
Human, Mouse, Rat (Species cross-reactivity determined by WB) |
|
Validated Applications |
WB, IHC-P, IP, FC, ICC/IF |
|
Purity |
ProA affinity purified IgG |
|
Form |
Liquid |
|
Swissprot ID |
P28482 |
|
Immunogen |
A synthetic peptide corresponding to the C-term of ERK2 was used as an immunogen. |
|
Storage Buffer |
PBS 59%, Sodium azide 0.01%, Glycerol 40%, BSA 0.05%. |
|
Storage Instructions |
Shipped on blue ice. Upon delivery, aliquot, and store at -20°C. Avoid freeze / thaw cycles. |
Data

All lanes: Anti-ERK2 antibody at 1:1,000 dilution
Predicted MW: 41 kDa
Observed MW: 42 kDa
Lane 1: JurKat
Lane 2: Hela
Lane 3: 293
Lane 4: A431
Lane 5: Raw264.7
Lane 6: 3T3
Lane 7: PC-12
Lysate at 10 μg per lane

All lanes: Anti-ERK2 antibody at 1:1,000 dilution
Predicted MW: 41 kDa
Observed MW: 42 kDa
Lane 1: Mu Brain
Lane 2: Mu Heart
Lane 3: Mu Kidney
Lane 4: Mu Liver
Lane 5: Rat Heart
Lane 6: Rat Kidney
Lane 7: Rat Liver
Lysate at 10 μg per lane
2nd Ab: GAR HRP(H+L) 1:10,000
Immunohistochemistry (Formalin/PFA PFA-fixed paraffin paraffin-embedded sections) analysis of endometrium cancer tissue labelling ERK2 with ERK2 Rabbit Monoclonal Antibody(ARA773).

Anti-ERK2 was immunoprecipitated from 0.4mg of A431 lysate with ERK2 Rabbit Monoclonal Antibody(ARA773) at 1:20 dilution.
2nd Ab: GAR HRP for IP 1:10,000
Lane 1: ERK2 Rabbit Monoclonal Antibody(ARA773) IP in A431 whole cell lysate
Lane 2: PBS instead of ERK2 Rabbit Monoclonal Antibody(ARA773) in A431 whole cell lysate
Lane3: A431 whole cell lysate, 10 μg(input)
Exposure: 120s

Overlay histogram showing Hela cells stained with ERK2 Rabbit Monoclonal Antibody(ARA773) (Red).
The cells were fixed with 4% paraformaldehyde (10 min) and then permeabilized with 0.1% Triton X-100 for 15 min.
The cells were then incubated in the antibody ERK2 Rabbit Monoclonal Antibody(ARA773), 1:200 dilution) in 1x PBS/1% BSA for 30 min at room temperature.
The secondary antibody used was a Goat Anti-Rabbit Alexa Fluor® 488 (IgG H+L) at 1:2,000 dilution for 20 min at room temperature.
Unlabelled sample (Black) was used as a control.

ERK2 Rabbit Monoclonal Antibody(ARA773) staining ERK2 in Hela cells by ICC/IF (Immunocytochemistry/Immunofluorescence).
Cells were fixed with paraformaldehyde, permeabilized with 0.1% Triton X-100 and blocked with 10% goat serum for half an hour at room temperature.
Samples were incubated with primary antibody (1:50) at 4°C.
An Alexa Fluor® 488-conjugated Goat Anti-Rabbit IgG polyclonal was used as the secondary antibody (1:500).
DAPI (blue) was used as the nuclear counter stain.
Control: PBS and secondary antibody, An Alexa Fluor® 488-conjugated Goat Anti-Rabbit IgG(1:500).
Storage
Store at 4°C short term. For long term storage, store at -20°C, avoiding freeze/thaw cycles.
Research Use Only
For Research Use Only. Not for use in diagnostic procedures.
New Products
